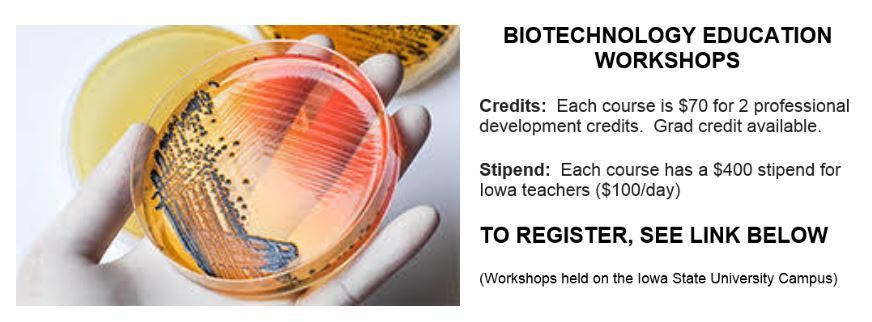
BIOTECH COURSES

May FCS/Human Services Newsletter


Welcome to May and your final school days of FY18! Prom has passed and graduations are all but behind us. I ran across this Edutopia article to help you navigate your end of the year duties so you can start off the new year ahead. I think it's worth a read! Check it out here!
Please let me know if you are retiring or changing schools so I can keep my distribution list accurate. An update on your replacement also helps me catch everyone on all things FCS and CTE that are so important for continuing the strength of our programming across the state.
I wish you all an enjoyable and restful summer break. Maybe I'll catch you along the way at a conference or workshop. Thank you and I hope you find some fun this summer!
Lisa
Summer workshops and Professional Development
Baking Builds Steam Workshop details

June 11 & 12, 2018
8:00 AM - 4:00 PM
Boone High School
Participants will be provided with practices that have been successful to impact student learning. The methods are essential to build on established baking curriculum. Teaching strategies will be offered for immediate implementation to engage students in active learning.
Go to AEA Professional Development Activity pages for information and to register.
18th Annual FREE Educator Conference for Personal Financial Literacy

June 28, 2018 – June 29, 2018
FFA Enrichment Center, DMACC
Breakfast and lunch provided!
You will not want to miss this key event designed especially for K-12 teachers – to help you connect with the materials, people and resources for understanding and teaching financial literacy.
For details and registration click HERE.
Iowa State University Biotechnology Courses details
Biotechnology Education Workshop I June 11-14, 2018
This workshop course is directed at science, agriculture, family and consumer sciences, and ISU Extension and Outreach educators who want to gain the basic knowledge and laboratory skills necessary to teach biotechnology in their classrooms.
Biotechnology Education Workshop II June 25-28, 2018
This advanced workshop is open to science, agriculture, family and consumer sciences, and ISU Extension and Outreach educators who have attended one of the previous biotechnology workshops. Bioethics Workshop I June 18-21, 2018
Bioethics Workshop I June 18-21, 2018
This course is designed for educators who want to incorporate discussion of ethical issues into existing science courses. Participants will create case studies designed to integrate ethical content in the science curriculum, and which also might be used to address such issues for extension audiences. The focus will be on ethical issues in science education, including especially agricultural biotechnology. Several other bioethics topics will also be covered.
For more information, use this link to the Iowa Biotech Educator classes.
Iowa State University Summer Textiles Class details

*ISU has assured me that this course will be held. Troy has resigned his position at Iowa State, but they will definitely have another instructor in place for this course. Email Michale Hansen with any questions on the course and registration.
DETAILS ON ANNUAL STATE FCS CONFERENCE IN AUGUST
Breakout with Family & Consumer Sciences
Sunday, August 5th - Tuesday, August 7th, 2018
Ames, Iowa
Co-Sponsored by Iowa Family and Consumer Sciences Educators and the Iowa Department of Education
Learn how to engage student learning through creating and implementing breakout boxes into various FCS content areas.
- Choose from over 20 breakout sessions.
- Participate in FCS content specific professional development.
- Network with other FCS educators.
- Learn ways to implement or enhance FCCLA in your classroom and school.
- Explore the Ames area with Human Services and FCS connected educational tours.
Click here for the CONFERENCE SCHEDULE.
Click here to REGISTER.
Conference Hotel Reservations: Call the Gateway Hotel and Conference Center to reserve your room today.
1-800-367-2637 Be sure to reference IFCSE Conference to get the conference rate.
Earn one graduate credit hour pending course approval from Viterbo University.
_______________________________________________________________________________________________
OTHER PD OF INTEREST TO FCS EDUCATORS:

Youth Mental Health First Aid is primarily for adults who regularly interact with young people. The course introduces common mental health challenges for youth, reviews typical adolescent development, and teaches a 5-step action plan for how to help young people in both crisis and non- crisis situations. Topics covered include anxiety, depression, substance use, disorders in which psychosis may occur, disruptive behavior disorders (including AD/HD), and eating disorders.
To find a course near you click HERE.

Windows Wear Teacher Workshop
New York City July 18-20
Click here for more information on WindowsWear education workshops.
_______________________________________________________________________________________________
OPPORTUNITY TO SHARE YOUR BEST RESEARCH ON THE BENEFITS OF FCS
ACTE's Techniques Journal Theme for April 2019: Making the Case for Family and Consumer Sciences
This issue of Techniques will highlight the ways in which Family and consumer sciences (FCS) educators have showcased the value of their programs, and demonstrate best practices that include utilizing data, research and other information and strategies to build program support. Family and consumer sciences education empowers students to use critical and creative thinking skills when faced with the challenges of balancing personal, home, family and work lives. This issue will also address how FCS is an important part of the career and technical education system. Proposals due Dec. 15: article submissions, Feb. 1.
This is an awesome opportunity to help FCS shine as a part of CTE! Let's fill this issue with the best articles they have ever read from some of our great experiences and classrooms in IOWA! We are going to help many an individual hear about and know about FCS!

AND.....when you are thinking about browsing for some new ideas or have some questions about FCS, classes, and activities for next year, don't forget about our Iowa FCS Educator FORUM. For information how to log on, click HERE.
KUDOS
Congratulations Joan Stekl from Cedar Rapids Washington High School for being recognized in Chicago at the ProStart's National Educator of Excellence Awards May 17th!

AND Congratulations to the DM Central Campus ProStart Management team for placing 10th in the nation at the National ProStart Competition in April. They are pictured below with May Schaben, Iowa Restaurant Association's Executive Director for the IRA's Education Foundation. The Waterloo West High Culinary team won a trip to Las Vegas at the National ProStart Invitational Opening Ceremony!!!
PLEASE NOMINATE!!!
Don't forget to nominate your wonderful colleagues for recognition at IFCSE's Annual Conference! Winners go on to the state Iowa ACTE awards that lead to Regional and National recognition. This is an excellent way to help spread the wonderful things that FCS does for our students and the community as well as say THANK YOU for a job well done!
The deadline was extended to June 18th -- PLEASE TAKE THE TIME TO NOMINATE! For more information, click HERE.
Financial Literacy as a Graduation Requirement effective July 1, 2019
Shan Seivert, DE Policy Liaison
We were anticipating amendments to be included in the Education Appropriations bill modifying certain provisions in SF 475, Education Omnibus. One of those provisions was including one half unit of financial literacy as a graduation requirement. The amendment included in SF 2415 allows the financial literacy credit to count as a half unit of social studies or other combination of coursework required in Iowa Code 256.11. The curriculum to be included in the course is outlined in the bill and it also states if the financial literacy course counts toward a social studies credit, the teacher need not hold a social studies endorsement. The financial literacy requirement is effective July 1, 2019.
Condition of CTE Report

| Lisa G. Stange, MA Ed Education Program Consultant Family and Consumer Sciences Bureau of Career and Technical Education Division of Community College & Workforce Preparation Iowa Department of Education Grimes State Office Building 400 East 14th Street Des Moines, IA 50319 515-242-5032 (O) 515-414-0864 (C) lisa.stange@iowa.gov Twitter: LGStange www.educateiowa.gov |
![]() |

